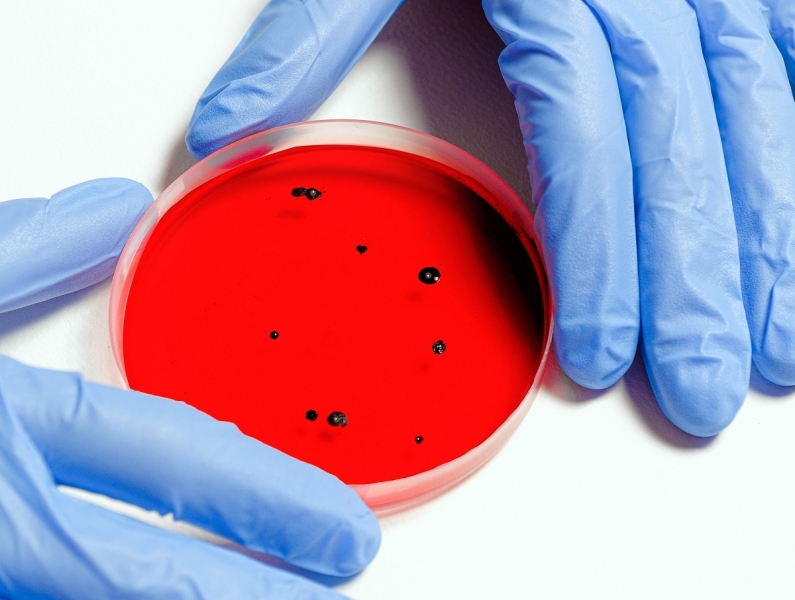
В Британии врачи обнаружили новый агрессивный штамм коронавируса у 16 человек

Мутирующий вирус был связан с поездками за границу.
Британские врачи нашли новый заразный штамм коронавируса. Пока в мире главенствует индийский штамм – «дельта», но в будущем его может вытеснить еще один более агрессивный вид коронавируса, предупреждают специалисты.
Как пишет РИА Новости, ссылаясь на газету Mirror, новый штамм коронавируса назвали B.1.621. Мутация обнаружена у 16 человек.
Большая часть из них была за рубежом, и могла привезти новый штамм «ковида» оттуда. Штамм нашли в Британии, США, Европе, Южной Америке.
Специалисты британского здравоохранения изучают данный вид штамма и пытаются понять, как он влияет на сам вирус.
Необходимо установить и насколько B.1.621. устойчив к любым противокоронавирусным вакцинам.
Предположительно, новый штамм может вызывать более серьезные последствия для организма, но это до конца не изучено.
В планах провести тестирование среди населения и установить, как мутация коронавируса распространяется.
Напомним, в России уже появился и «гамма» – штамм коронавируса из Бразилии. Он также считается агрессивным и более заразным.
Как писал ранее Topnews, Всемирная организация здравоохранения предупредила, что миру угрожает еще более опасный штамм коронавируса, чем сейчас есть.
Он сможет «увернуться» от существующих вакцин, и тогда мир отбросит в самое начало, к началу пандемии, когда любые средства против вируса были бесполезны.













